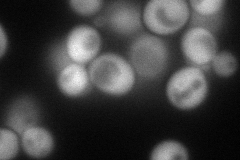
YPL081W
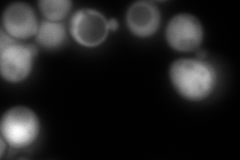
YPL081W
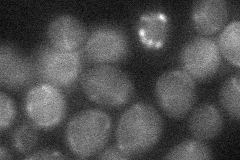
YPL081W
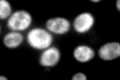
YPL081W

View description
Protein component of the small (40S) ribosomal subunit; nearly identical to Rps9Bp and has similarity to E. coli S4 and rat S9 ribosomal proteins
Localization:
Intensity:
Fold change:
Significance:
-
C’ GFP library in SD

cytosol685.1 -
N' NOP1pr-GFP in SD
cytosol111.76 -
N' TEF2pr-mCherry in SD

cytosol41.0355 -
N' NATIVEpr-GFP in SD
cytosol620.366 -
N' TEF2pr-VC and Cyto-VN in SD
below threshold22.8951 -
C’ GFP library in SD+DTT

cytosol381.030.55No -
C’ GFP library in SD+H2O2

cytosol609.780.89No -
C’ GFP library in Starvation Media
cytosol745.271.08No -
C’ GFP library on the background of Pup2-DaMP

cytosol -
C’ GFP library on the background of CCT mutant

cytosol606.5030.885272No
